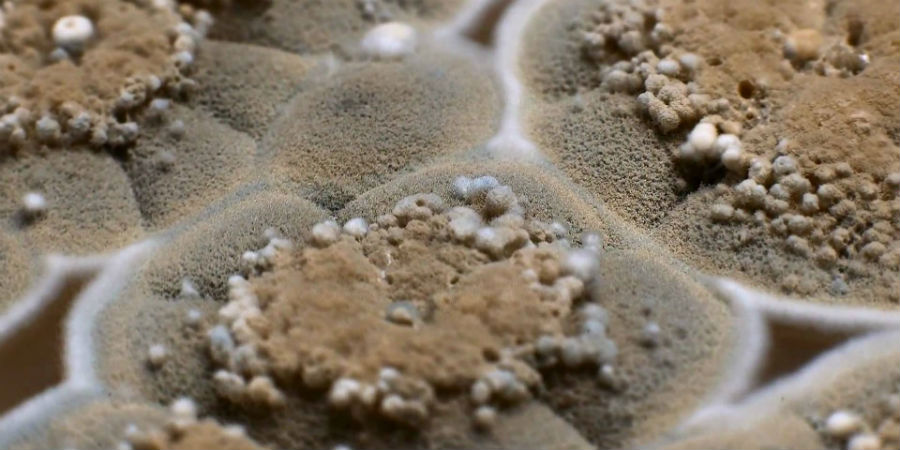

Schimmels spelen de hoofdrol in dit nagebootste intro van onze favoriete HBO-serie, Game of Thrones.
Sommige mensen worden daadwerkelijk door alles herinnerd aan de hitserie Game of Thrones. Zelfs bij het zien van filmpjes over, jawel, schimmels. Een die-hard fan zag in deze time-lapse van fotograaf Nick Lariontsev namelijk de intro van de serie. Hij zette de titelsong van de serie onder het filmpje, monteerde het een en ander en toen zagen wij het ook:
In het filmpje tref je verschillende schimmels aan die enkele dagen op de voet zijn gevolgd. Wil je weten welke geslachten en soorten het zijn? Tech Insider zette ze voor je op een rijtje.
Bronnen: Gizmodo, Tech Insider